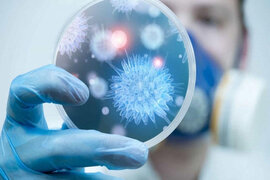
.

Xəbərlər

Süni intelektin də yuxuya ehtiyacı var imiş – ALİMLƏR
Son zamanlar gündəmdə olan süni intelektin də yuxuya ehtiyacı olduğu üzə çıxıb. Alimlər onun neyro şəbəsəkəsinin stabil işləməsi üçün insan beynində olduğu kimi, periodik olaraq istirahətə və "yuxuya getməyə" tələbat
Viruslar immunitetimizdən güclü ola bilməz - Alimlər nə tövsiyə edir?
Koronavirus öz bədxah yürüşünü davam edir. COVİD-lə əlaqəli vəziyyət aydın göstərir ki, biz bu virusla hələ uzun müddət yaşamalı olacayıq. İnsan müxtəlif törədicilərlə daim təmasdadır. Mikroorqanizmlərin mövcüdluğu insanı

"Koronavirusu Amerika və çinlilər istehsal edib" - Vaksinoloq alim
Koronavirusun genetikası onun təbii mənşəli olmadığını, Çin və ABŞ alimləri tərəfindən hazırlandığını göstərir. -a istinadən bildirir ki, norveçli vaksinoloq Birger Sörensen açıqlama verib. "Quarterly Review of Biophysics"

Ukraynada həkim çatımazlığı yaşanır
Koronavirus pandemiyası şəraitində Ukraynada həkim çatışmazlığı müşahidə edilir. Xüsusən epidemioloq çatışmazlığı 48 faiz, həkim-laborantların, həkim-gigiyenistlərin çatışmazlığı 51 faiz, virusoloqların çatışmazlığı isə 4

Qanınızı adi soğanla necə təmizləyə bilərsiz? - SADƏ METOD
Bütün orqan və sistemləri təmizləyən, oksigenlə təmin edən qandır. Qan normal tərkibdə və miqdarda olmasa xəstəliklər buketi yaranır. -a istinadən məhz qanın keyfiyyətlərini yaxşılaşdıran, təmizləyən sadə soğan metodunu təqdi

"Şiş ağciyərimə yayıldı" - Tünzalə
Əməkdar artist Tünzalə Əliyeva səhhətinin daha da pisləşdiyini deyib. axşam.az-a istinadən bildirir ki, xərçəngdən əziyyət çəkən aktrisa şişin ağciyərlərinə yayıldığını bildirib:. "Hər birinizə etdiyiniz dualarınıza

"Danışa bilmirəm, boğuluram..." - Koronavirusa yoluxan xəstələrin olduğu xəstəxanadan REPORTAJ - VİDEO
"ARB 24" telekanalı xəstəxanada koronavirusdan əziyyət çəkənlər haqqında reportaj hazırlayıb. reportajı təqdim edir

Azərbaycanlıların da əziyyət çəkdiyi - REVMATOİD ARTRİT BƏLASI
Revmatoid artrit - Orqanizmin öz hüceyrələrinə düşmən kəsildiyi qeyri-adi, mürəkkəb bir xəstəlikdir. Son zamanlar çox yaşlı insanları, qadınları, eləcə də artıq orta yaşlı insanları da qəfil yaxalayan autoimmun xəstəliklərində

İsti hava şəraitində soyuq qidaların qəbul edilməsi uşaqlarda boğaz ağrılarına səbəb ola bilər
Uşaqlarda boğaz ağrılarının olması valideynləri çox narahat edir. Udqunarkən kəskin ağrı verən narahatlıq əksər hallarda bakteriyaların səbəb olduğu iltihablanma nəticəsində yaranır, yüksək temperatura gətirib çıxarır. bildiri

LİPOMA şişləri nədir, niyə əmələ gəlir? - MÜALİCƏSİ
Çox adamda rast gəlinən dərialtı kiçik, orta, bəzən böyüyən piy toxumasından yaranan şişlərdir. Lipomanın alt qatı, yəni kökü hətta daha dərin, əzələni də keçərək sümüyə kimi çata bilər. -a istinadən bu maraqlı şiş növünü

İsti havada bu məhsulları yeyin - həm sərinləşdirir, həm qoruyur
a istinadən bildirir ki, yay aylarında qəbul edəcəyimiz bu məhsullar həm sərinləşdirir, həm orqanizmimizi vitaminlə təmin edir, həm də çəkimizi qorumağa kömək edə bilər. Bəs onlar hanıslardır?. 1. Qarğıdalı. Təzə qarğıdal

Palma yağından istifadə edilməsi piylənmə və xroniki xəstəliklərin inkişafına səbəb olur
İndoneziya, Malayziya, Braziliya və Afrika ölkələrində yetişən palma ağacının meyvəsindən hazırlanan yağ ən ucuz bitki yağıdır. Elə buna görə də onun istifadə arealı durmadan artır. Dünyada il ərzində 50 milyon ton civarınd

Eynək və linzadan istifadə qaydaları
Eynəklərin yaranma tarixi təxminən doqquz əsr əvvələ gedib çıxır. O vaxtlar görmə qabiliyyəti zəif olanlar üçün hazırlanmış gözlüklər bu gün həm də aksesuar kimi istifadə edilir. Təyinatına, rənginə və formasına görə eynəklə

Koronavirus palata və çarpayılarda 5 gün yaşaya bilir - ALİMLƏR
Böyük Britaniyanın virus DNT-si üzrə institutunun alimləri koronaviruslu xəstələrin gətirildiyi xəstəxanaların palatalarında, əşyalar və çarpayılar səthində virusun nə qədər yaşaya bilməsini dəqiqləşdirib. Onlar xəstəxan

Tibbi maska və sosial məsafə koronavirusdan necə qoruyur? - Beynəlxalq ARAŞDIRMA
Həftə sonu sərt karantin rejiminin tətbiqindən sonra həyat yenidən normala döndü. Hərçənd, ölkədə koronavirusa yoluxma statistikasının artan templə davam etməsi fonunda vətəndaşların həyati üçün risk olduqca yüksəkdir. Hə

Qlükoza - min bir dərdin dərmanı
QLÜKOZA - ilk dəfə elmi yolla ingiltərəli alim Vilyam Praut tərəfindən 1802-ci ildə kəşf edilmişdir. QLÜKOZA-nın başqa adı üzüm şəkəridir. QLÜKOZA bütün orqanizm üçün faydalı olmaqla bərabər, sinir sistemi üçün də çox vacibdir.

Baş ağrısını sakitləşdirməyin 7 təbii vasitəsi
Son illərdə ağrı kəsicilərə olan tələblər çoxaldığına görə insanlar təbii vasitələrə üstünlük verir. xəbər verir ki, ağrı kəsici dərman vasitələri olmadığı halda da ağrıları sakitləşdirmək mümkündür. Xüsusilə də baş ağrısın

Koronavirus beyinə nüfuz edir - ARAŞDIRMA
SARS-CoV-2 virusu nöropilin-1 zülalının köməyi ilə beynə daxil olur. xəbər verir ki, bu barədə "bioRxiv" preprint onlayn kitabxanasında yayımlanan bir araşdırmada bildirilib. Bir qrup avropalı alim aşkar edib ki

COVID-19 xəstələrində sağaldıqdan sonra bəzi simptomların davam etdiyi müəyyənləşib
COVID-19 xəstələrinin bəzilərində sağaldıqdan sonra sinə hissəsində ağrılar, nəfəs darlığı, öskürək və ishal kimi simptomların davam etdiyi müəyyən olunub. AZƏRTAC-a istinadən bildirir ki, bu barədə Türkiyənin İstanbuld

Tez-tez əl yumaq zərərlidir? - Mütəxəssis AÇIQLADI
"Virusların yayılmasına qarşı mübarizədə əsas vasitə olan əl yumaq da zərərli ola bilər. Bəzi hallarda gigiyena qaydalarının tərsi əks nəticə verə bilər". xəbər verir ki, bunu allerqoloq-immunoloq həkim Alekse

Min bir dərdin DƏRMANI: özü kimi yarpaqları da... - VİDEO
Orqanizm üçün faydalı məhsullardan biri də moruq yarpaqlarıdır. həmin yarpaqların faydalarını təqdim edir:. 1. Güclü iltihabəleyhinə təsir göstərir. Soyuqdəymə və qripp zamanı moruq yarpaqlarını çay kimi dəmləyib bal əlav

Sürətlə arıqladan UNİKAL VASİTƏ
Bir çox insan artıq çəkidən sürətli və sağlam şəkildə xilas olmağın yollarını axtarır. xəbər verir ki, antioksidan qaynaqlı, həzm sistemini sürətləndirən və aclıq hissini minimuma endirən bu faydalı çayı gündə 2 fincan içməkl

TƏBİB binaların liftindən istifadə edən sakinlərə müraciət etdi
Tibbi Ərazi Bölmələrinin İdarəetmə Birliyi (TƏBİB) COVID-19 infeksiyasından qorunmaq üçün vətəndaşlara daha bir müraciət edib. Trend-ə istinadən bildirir ki, virusdan qorunmaq üçün iş yerlərində, müxtəlif ofis binalarınd

Çinli ekspert: Koronavirusa qarşı peyvənd...
Çinin respirator xəstəliklər üzrə tanınmış eksperti Con Nanşan yeni növ koronavirusa (COVID-19) qarşı peyvəndin payızın əvvəlində ilkin istifadəsinin mümkün ola biləcəyini açıqlayıb. AZƏRTAC-a istinadən bildirir ki, Çind

 Hakışta
Hakışta Mükəmməl seks üçün yataqdakı QAYDALAR
Mükəmməl seks üçün yataqdakı QAYDALAR İdeal Dieta: 1 həftəyə 5 kq arıqla!
İdeal Dieta: 1 həftəyə 5 kq arıqla! Cəfərinin insan orqanizminə inanılmaz faydaları
Cəfərinin insan orqanizminə inanılmaz faydaları Qara zirə (Çörək otunun) faydaları
Qara zirə (Çörək otunun) faydaları Qarazirə hər dərdin çarəsi olan bitki
Qarazirə hər dərdin çarəsi olan bitki DİQQƏT ! Yuxuda pişik görmüsüzsə ..Ağır xəstəlik gözləyir
DİQQƏT ! Yuxuda pişik görmüsüzsə ..Ağır xəstəlik gözləyir Ən güclü təbii antibiotik: Udi hindi bitkisinin faydaları
Ən güclü təbii antibiotik: Udi hindi bitkisinin faydaları Bu çərəz mədə yanmasını anında kəsir: Cəmi bir ovuc kifayətdir
Bu çərəz mədə yanmasını anında kəsir: Cəmi bir ovuc kifayətdir Xərçənglə bağlı çağırış
Xərçənglə bağlı çağırış Hər gün etdiyimiz, amma ömrümüzü qısaldan VƏRDİŞLƏR: Çoxları bunu bilmir
Hər gün etdiyimiz, amma ömrümüzü qısaldan VƏRDİŞLƏR: Çoxları bunu bilmir Survivor' Serenay bu azərbaycanlı ilə sevgilidir
Survivor' Serenay bu azərbaycanlı ilə sevgilidir Dəridəki yara izlərini yox edən MÖCÜZƏVİ YAĞ: Faydasını çox az adam bilir
Dəridəki yara izlərini yox edən MÖCÜZƏVİ YAĞ: Faydasını çox az adam bilir Şam yeməyini bu saatda yeyən xəstəxananın yolunu unudur
Şam yeməyini bu saatda yeyən xəstəxananın yolunu unudur Bu testdən keçməyən yumurtanı əsla yeməyin
Bu testdən keçməyən yumurtanı əsla yeməyin